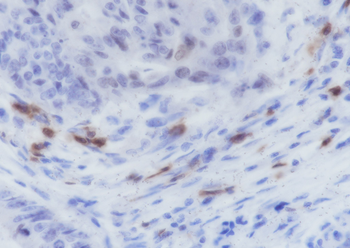
产品细节图片2

相关产品推荐更多 >
万千商家帮你免费找货
0 人在求购买到急需产品
- 详细信息
- 文献和实验
- 技术资料
- 抗体名:
ITGAE/CD103 Recombinant Rabbit Monoclonal Antibody抗体
- 抗体英文名:
ITGAE/CD103 Recombinant Rabbit Monoclonal Antibody
- 靶点:
ITGAE
- 浓度:
1mg/ml
- 应用范围:
IF, IHC-Fr, IHC-P
- 宿主:
Rabbit
- 适应物种:
Human
- 保质期:
6-12个月
- 抗原来源:
详询
- 目录编号:
orb1152024
- 级别:
科研级
- 库存:
88
- 供应商:
biorbyt
- 标记物:
Unconjugated
- 克隆性:
Recombinant
- 形态:
Liquid
- 亚型:
IgG
- 免疫原:
KLH conjugated synthetic peptide derived from human ITGAE/CD103
- 规格:
25 ul
别名:alpha-E1; alpha-M290; aM290; Antigen CD103; CD 103; CD103; CD103 antigen; HML 1 antigen; HML1 antigen; Human mucosal lymphocyte antigen 1; Human mucosal lymphocyte antigen 1, alpha subunit; Huminae; Integrin alpha E heavy chain; Integrin alpha E light chain; Integrin alpha E, epithelial-associated; Integrin alpha E1; Integrin alpha IEL; Integrin alpha M290; Integrin, alpha E(antigen CD103, human mucosal lymphocyte antigen 1; alpha polypeptide); Integrin, alpha E; ITGAE; MGC141996; MGC183601; Mucosal lymphocyte 1 antigen; Mucosal lymphocyte antigen 1;
免疫原:KLH conjugated synthetic peptide derived from human ITGAE/CD103
克隆性:C4G1
分子量:110/128 kDa
应用稀释比例:IHC-P=1:50-200, IHC-F=1:50-200, IF=1:50-200
防腐剂:0.01M TBS (pH7.4) with 1% rAlbumin, 0.02% Proclin300 and 50% Glycerol.
纯化:Affinity purified by Protein A
保存说明:Maintain refrigerated at 2-8°C for up to 2 weeks. For long term storage store at -20°C in small aliquots to prevent freeze-thaw cycles.
UniProt ID:P38570
Note:For research use only.

风险提示:丁香通仅作为第三方平台,为商家信息发布提供平台空间。用户咨询产品时请注意保护个人信息及财产安全,合理判断,谨慎选购商品,商家和用户对交易行为负责。对于医疗器械类产品,请先查证核实企业经营资质和医疗器械产品注册证情况。
文献和实验到 PVDF 膜上,同时减少蛋白不必要降解,这对于最终获得清晰、可信结果也是需要考虑因素。抗体信息:1.ACC1, Recombinant Rabbit monoclonal IgG. HuaAn. HuaAn biotechnology , inc.2.ATGL, Mouse mAb IgG1, Cat#:RT1058. HuaAn biotechnology , inc.3.p-PERK(Thr981), Rabbit Polyclonal IgG primary antibodies, Cat
我准备做凋亡过程中CASPASE 3的变化,用WESTERN检测。我准备买SANTA CRUZ的抗体。有两种,一种是单抗,另一种是多抗。具体如下: 1.caspase-3 (E-8): sc-7272 SOURCE Caspase-3 (E-8) is a mouse monoclonal IgG2a antibody corresponding to amino acids 1-277 representing the full length precursor form
Protein Purification: Assays, Specific Activity, Initial Fractionation
The nitrocellulose is then incubated with a second antibody which is specific for the first antibody. For example, if the first antibody was raised in rabbits, the second antibody might be termed "goat anti-rabbit immunoglobulin". What this means is that rabbit
技术资料暂无技术资料 索取技术资料










